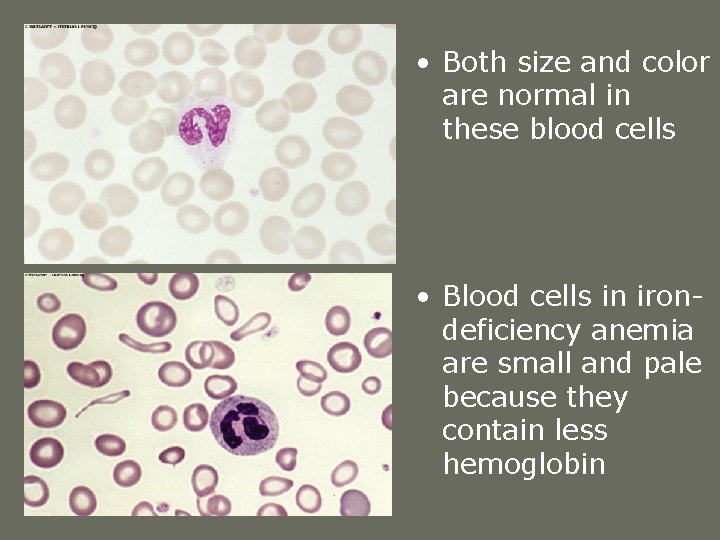
• Both size and color are normal in these blood cells • Blood • Both size and color are normal in these blood cells • Blood

The Trace Minerals Copyright 2005 Wadsworth Group a

- Slides: 33
The Trace Minerals Copyright 2005 Wadsworth Group, a division of Thomson Learning
The Trace Minerals Copyright 2005 Wadsworth Group, a division of Thomson Learning
Trace Minerals Iron Iodine Fluoride Manganese Molybdenum Nickel Boron Zinc Selenium Copper Chromium Arsenic Silicon Cobalt
Iron • Ferrous (Fe++) – Reduced • Ferric (Fe+++) – Oxidized • Chief functions in the body – Part of the protein hemoglobin, which carries oxygen in the blood – Part of the protein myoglobin in muscles, which makes oxygen available for muscle contraction – Necessary for the utilization of energy as part of the cells’ metabolic machinery Copyright 2005 Wadsworth Group, a division of Thomson Learning
Iron Absorption Copyright 2005 Wadsworth Group, a division of Thomson Learning
Iron Sources – two forms of iron in food 1. Heme iron – meats, poultry, fish; readily absorbed 2. Nonheme iron – plants foods; less absorbed a. Absorption enhanced by Vitamin C b. Absorption diminished by phytates, oxalates, and tannic acid
Iron: Heme vs. Nonheme Copyright 2005 Wadsworth Group, a division of Thomson Learning
Iron • 2001 RDA – Men: 8 mg/day – Women (19 -50 years): 18 mg/day – Women (51+ years): 8 mg/day • Upper level for adults: 45 mg/day • Significant sources – Red meats, fish, poultry, shellfish, eggs – Legumes, dried fruits Copyright 2005 Wadsworth Group, a division of Thomson Learning
Iron • Iron deficiency is the most common nutrient deficiency worldwide • Can occur if inadequate intake or blood loss • Females are prone due to menstruation, lower iron intake & pregnancy • Preschoolers also at risk due to high milk diets Copyright 2005 Wadsworth Group, a division of Thomson Learning
Iron • Deficiency symptoms – Microcytic, hypochromic anemia (low Hgb & Hct): weakness, fatigue, headaches – Impaired work performance and cognitive function – Impaired immunity – Pale skin, nailbeds, mucous membranes, and palm creases – Concave nails – Inability to regulate body temperature – Pica (craving for ice, clay, paste, and other non-food substances) Copyright 2005 Wadsworth Group, a division of Thomson Learning
• Both size and color are normal in these blood cells • Blood cells in irondeficiency anemia are small and pale because they contain less hemoglobin
Iron • Toxicity – “iron overload”; more common in men -Hemochromatosis – genetic defect -Hemosiderosis – chronic ingestion of too much iron; more common in alcoholics -Iron poisoning – acute toxicity from overdose of iron supplements; can be deadly in small children • Toxicity symptoms – GI distress – Iron overload: infections, fatigue, joint pain, skin pigmentation, organ damage Copyright 2005 Wadsworth Group, a division of Thomson Learning
Zinc Chief functions in the body – Part of many enzymes, esp. enzymes for transfer of carbon dioxide – Associated with the hormone insulin – Involved in making genetic material and proteins – Important to wound healing, taste perception, reproduction (the making of sperm), vision (transports and activates Vit. A) & immune function Copyright 2005 Wadsworth Group, a division of Thomson Learning
Zinc • 2001 RDA – Men: 11 mg/day – Women: 8 mg/day • Upper level for adults: 40 mg/day • Significant sources – Protein-containing foods – Red meats, shellfish – Whole grains Copyright 2005 Wadsworth Group, a division of Thomson Learning
Zinc • Deficiency symptoms – In children, growth retardation and delayed sexual maturation – Impaired immune function – Hair loss – Eye and skin lesions – Loss of appetite and abnormal taste – Depressed immune function and poor wound healing - Night blindness
Zinc • Toxicity – not likely, unless supplement abuse • Toxicity symptoms – Loss of appetite, impaired immunity, low HDL, copper and iron deficiencies Copyright 2005 Wadsworth Group, a division of Thomson Learning
Iodine • Chief functions in the body – A component of two thyroid hormones that help to regulate growth, development, and metabolic rate • 2001 RDA for adults: 150 g/day • Upper level: 1100 g/day
Iodine • Significant sources – Iodized salt, seafood, bread, dairy products, plants grown in iodinerich soil and animals fed those plants (content of iodine in soils affects food content) Copyright 2005 Wadsworth Group, a division of Thomson Learning
Iodine • Deficiency disease -Simple goiter-enlarged thyroid; affects 200 million people worldwide -Creatinism- severe mental and physical retardation in infants • Deficiency symptoms – Underactive thyroid gland, goiter • Toxicity symptoms – Underactive thyroid gland, elevated TSH, goiter (also causes enlarged thyroid gland) Copyright 2005 Wadsworth Group, a division of Thomson Learning
Selenium • Chief functions in the body – Defends against oxidation – Regulates thyroid hormone • 2000 RDA for adults: 55 g/day • Upper level for adults: 400 g/day • Significant sources – Seafood, meat – Whole grains, vegetables (depending on soil content) Copyright 2005 Wadsworth Group, a division of Thomson Learning
Selenium • Deficiency symptoms – Predisposition to heart disease (cardiomyopathy) characterized by cardiac tissue becoming fibrous (Keshan disease) • Toxicity symptoms -Highly toxic, esp. supplement abuse – Loss and brittleness of hair and nails – Skin rash, fatigue, irritability, and nervous system disorders – Garlic breath odor Copyright 2005 Wadsworth Group, a division of Thomson Learning
Copper • Chief functions in the body – Component of enzymes involved in the absorption and use of iron in the formation of hemoglobin – Part of several enzymes necessary for collagen, healing wounds, maintaining nerve fiber’s myelin sheath • Upper level for adults: • 2001 RDA for adults: 900 g/day 10, 000 g/day (10 mg/day) Copyright 2005 Wadsworth Group, a division of Thomson Learning
Copper • Significant sources – Seafood – Nuts, whole grains, seeds, legumes • Deficiency symptoms (rare) – Anemia, bone abnormalities • Toxicity symptoms-only in supplement abuse & abnormal storage in Wilson’s disease -Liver damage Copyright 2005 Wadsworth Group, a division of Thomson Learning
Manganese • Chief functions in the body – Cofactor for several enzymes – Component of bones and glands • 2001 AI – Men: 2. 3 mg/day – Women: 1. 8 mg/day • Upper level for adults: 11 mg/day Copyright 2005 Wadsworth Group, a division of Thomson Learning
Manganese • Significant sources – Nuts, whole grains, leafy vegetables, tea • Deficiency symptoms – Rare; requirements are low • Toxicity symptoms – Nervous system disorders – Has occurred in miners inhaling large quantities of dust causes brain damage Copyright 2005 Wadsworth Group, a division of Thomson Learning
Fluoride • Chief functions in the body – Involved in the formation of bones and teeth – Helps to make teeth resistant to decay • 1997 AI – Men: 3. 8 mg/day – Women: 3. 1 mg/day • Upper level for adults: 10 mg/day Copyright 2005 Wadsworth Group, a division of Thomson Learning
Fluoride • Significant sources – Drinking water (if fluoride containing or fluoridated) – Tea, seafood • Deficiency symptoms – Susceptibility to tooth decay – Higher incidence of dental caries • Toxicity symptoms – Fluorosis (pitting and discoloration of tooth enamel) Copyright 2005 Wadsworth Group, a division of Thomson Learning
U. S. Population With Fluoridated Water Copyright 2005 Wadsworth Group, a division of Thomson Learning
Chromium • Chief functions in the body – Enhances insulin action – CHO & lipid metabolism • 2001 AI -Men: 35 g/day – Women: 25 g/day • Significant sources – Meats (especially liver) – Whole grains, brewer’s yeast Copyright 2005 Wadsworth Group, a division of Thomson Learning
Chromium • Deficiency symptoms – Diabetes-like condition; mimics symptoms of diabetes, especially in elderly • Toxicity symptoms – None reported Copyright 2005 Wadsworth Group, a division of Thomson Learning
Trace Minerals • Others – Molybdenum, Nickel, Cobalt, Silicon, Boron, Arsenic • Known to be important & essential for animals but human requirements under study • No recommendation is necessary since there is no evidence that intake by humans is ever limiting and unestablished roles in health maintenance